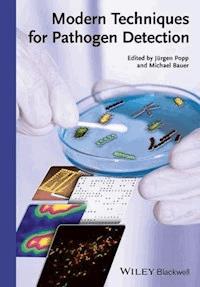
Modern Techniques for Pathogen Detection -  - E-Book

Modern Techniques for Pathogen Detection E-Book
120,99 €
Mehr erfahren.
- Herausgeber: Wiley-VCH
- Kategorie: Wissenschaft und neue Technologien
- Sprache: Englisch
This outstanding overview sets a new standard for a methods book on pathogen detection. The first chapter provides an outline of currently used routine methods, including their background, strengths and weaknesses, as well as comparing them to newer methods. The following chapters then cover novel methods already in wide use and which are still more experimental for routine purposes.
An invaluable resource for all medical laboratories and clinical institutions dealing with infectious diseases.
Sie lesen das E-Book in den Legimi-Apps auf:
Seitenzahl: 648
Veröffentlichungsjahr: 2015
Ähnliche
Table of Contents
Cover
Related Titles
Title Page
Copyright
Preface
List of Contributors
Chapter 1: Unmet Medical Needs in Life-Threatening Infections – Caring for the Critically Ill
1.1 Life Threatening Infections and Sepsis – Defining the Problem
1.2 Sepsis as a “Hidden Healthcare Disaster”
1.3 Microorganisms and Types of Infection Triggering Sepsis
1.4 Emerging Problems Related to Resistance in Bacterial Infections
1.5 The Role of Fungi and Viruses
1.6 The Need for New Approaches in Diagnostics of Life-Threatening Infection and Sepsis
1.7 Rapid and Sensitive Culture-Independent Strategies to Identify Blood Stream Infection
1.8 Beyond Infection – Profiling the Immune Response of the Septic Host
1.9 Host Factors Contributing to Pathogenesis of Sepsis
References
Chapter 2: Identification Methods – An Overview
2.1 Taxonomy of Pathogenic Organisms
2.2 Microscopic Methods
2.3 Culture-Based Methods
2.4 Nucleic Acid-Based Techniques
2.5 Serology
2.6 Conclusions and Perspectives
References
Chapter 3: Nucleic Acid Amplification Techniques
3.1 Introduction
3.2 The Basic PCR Protocol
3.3 Primer Design
3.4 Modified End-Point PCR Protocols
3.5 Non-PCR NAT: Isothermal Amplification Protocols
3.6 Quantitative PCR
3.7 Controls, Probing, and General Aspects of Result Interpretation
3.8 Preanalytics
3.9 Fields of PCR Application
3.10 Microbial Trace Detection in BSI, Ascites, and Synovial Fluids
3.11 Upcoming Routine Solutions – Dawn of Assay Automation
3.12 Conclusion and Perspective
Acknowledgment
References
Chapter 4: DNA Microarrays for Pathogen Detection
4.1 Introduction
4.2 DNA Microarrays for the Detection of Bacterial Pathogens
4.3 Antibiotic Resistance Detection
4.4 DNA Microarrays for Virus Diagnostics
4.5 DNA Microarrays for Detection of Fungal Pathogens
4.6 DNA Microarrays for Parasite Diagnostics
4.7 Conclusion an Outlook
References
Chapter 5: MALDI-ToF
5.1 Introduction
5.2 MALDI-ToF Technology
5.3 Bacterial Identification Using Mass Spectrometry
5.4 Culture-Independent Rapid Identification of Clinical Pathogens
5.5 Antibiotic Susceptibility Testing Using Mass Spectrometry
References
Chapter 6: IR and Raman Spectroscopy for Pathogen Detection
6.1 Introduction
6.2 Bulk Analysis
6.3 Excitation with Visible Wavelengths
6.4 UV-Resonance Raman Spectroscopy
6.5 Single-Cell Analyses
6.6 Conclusion and Outlook
References
Chapter 7: FISH
7.1 Introduction
7.2 FISH Techniques
7.3 Clinical Implications of PNA FISH
7.4 Summary and Outlook
References
Chapter 8: Conclusions
Index
End User License Agreement
Pages
xi
xii
xiii
xv
xvi
xvii
xviii
xix
1
2
3
4
5
6
7
8
9
10
11
12
13
14
15
16
17
18
19
20
21
22
23
24
25
26
27
28
29
30
31
32
33
34
35
36
37
38
39
40
41
42
43
44
45
46
47
48
49
50
51
52
53
55
56
57
58
59
60
61
62
63
64
65
66
67
68
69
70
71
72
73
74
75
76
77
78
79
80
81
82
83
84
85
86
87
88
89
90
91
92
93
94
95
96
97
98
99
100
101
102
103
104
105
106
107
108
109
110
111
113
114
115
116
117
118
119
120
121
122
123
124
125
126
127
128
129
130
131
132
133
134
135
136
137
138
139
140
141
142
143
144
145
146
147
148
149
150
151
152
153
154
155
156
157
158
159
160
161
162
163
164
165
166
167
168
169
170
171
172
173
174
175
176
177
178
179
180
181
182
183
184
185
186
187
188
189
190
191
192
193
194
195
196
197
198
199
200
201
202
203
204
205
206
207
208
209
210
211
212
213
214
215
216
217
218
219
220
221
222
223
224
225
226
227
228
229
230
231
232
233
234
235
236
237
238
239
240
241
242
243
244
245
246
247
248
249
250
251
252
253
254
255
256
257
258
259
260
261
262
263
264
265
266
267
268
269
270
271
272
273
274
275
276
277
278
279
280
281
282
283
284
285
286
287
288
289
290
291
292
293
294
295
296
297
298
299
300
301
302
303
304
305
306
307
308
309
310
311
312
313
314
315
316
317
318
319
320
321
323
324
325
326
327
328
329
330
Guide
Cover
Table of Contents
Preface
Begin Reading
List of Illustrations
Figure 1.1
Figure 1.2
Figure 1.3
Figure 1.4
Figure 1.5
Figure 2.1
Figure 2.2
Figure 2.3
Figure 2.4
Figure 2.5
Figure 2.6
Figure 3.1
Figure 3.2
Figure 3.3
Figure 3.4
Figure 3.5
Figure 3.6
Figure 4.1
Figure 4.2
Figure 4.3
Figure 4.4
Figure 5.1
Figure 5.2
Figure 5.3
Figure 5.4
Figure 5.5
Figure 5.6
Figure 6.1
Figure 6.2
Figure 6.3
Figure 6.4
Figure 6.5
Figure 6.6
Figure 6.7
Figure 6.8
Figure 6.9
Figure 6.10
Figure 6.11
Figure 6.12
Figure 7.1
Figure 7.2
Figure 7.3
Figure 7.4
List of Tables
Table 1.1
Table 1.2
Table 3.1
Table 3.2
Table 3.3
Table 4.1
Table 4.2
Table 4.3
Table 4.4
Table 4.5
Table 4.6
Table 4.7
Table 7.1
Related Titles
Keller, A., Meese, E. (eds.)
Nucleic Acids as Molecular Diagnostics
2015
ISBN: 978-3-527-33556-5, also available in digital formats
Vandenabeele, P.
Practical Raman Spectroscopy - An Introduction
2013
ISBN: 978-0-470-68318-7, also available in digital formats
Hillenkamp, F., Peter-Katalinic, J. (eds.)
MALDI MSA Practical Guide to Instrumentation, Methods and Applications
2014
ISBN: 978-3-527-33331-8, also available in digital formats
Elschner, M., Cutler, S., Weidmann, M., Butaye, P. (eds.)
BSL3 and BSL4 AgentsEpidemiology, Microbiology, and Practical Guidelines
2012
ISBN: 978-3-527-31715-8, also available in digital formats
Edited by Jürgen Popp and Michael Bauer
Modern Techniques for Pathogen Detection
The Editors
Prof. Dr. Jürgen Popp
Friedrich-Schiller University Jena and Abbe Center of Photonics
Institute of Physical Chemistry
Helmholtzweg 4
07743 JenaandLeibniz Institute of Photonic Technology
Albert-Einstein-Straße 9
07745 Jena
Germany
Prof. Dr. Michael Bauer
Jena University Hospital
Department of Anesthesiology
and Intensive Care MedicineandCenter for Sepsis Control and Care (CSCC)
Erlanger Allee 101
07747 Jena
Germany
Limit of Liability/Disclaimer of Warranty: While the publisher and author have used their best efforts in preparing this book, they make no representations or warranties with respect to the accuracy or completeness of the contents of this book and specifically disclaim any implied warranties of merchantability or fitness for a particular purpose. No warranty can be created or extended by sales representatives or written sales materials. The Advice and strategies contained herein may not be suitable for your situation. You should consult with a professional where appropriate. Neither the publisher nor authors shall be liable for any loss of profit or any other commercial damages, including but not limited to special, incidental, consequential, or other damages.}
Library of Congress Card No.: applied for
British Library Cataloguing-in-Publication Data
A catalogue record for this book is available from the British Library.
Bibliographic information published by the Deutsche Nationalbibliothek
The Deutsche Nationalbibliothek lists this publication in the Deutsche Nationalbibliografie; detailed bibliographic data are available on the Internet at <http://dnb.d-nb.de>.
© 2015 Wiley-VCH Verlag GmbH & Co. KGaA,
Boschstr. 12, 69469 Weinheim, Germany
Wiley-Blackwell is an imprint of John Wiley & Sons, formed by the merger of Wiley's global Scientific, Technical, and Medical business with Blackwell Publishing.
All rights reserved (including those of translation into other languages). No part of this book may be reproduced in any form – by photoprinting, microfilm, or any other means – nor transmitted or translated into a machine language without written permission from the publishers. Registered names, trademarks, etc. used in this book, even when not specifically marked as such, are not to be considered unprotected by law.
Print ISBN: 978-3-527-33516-9
ePDF ISBN: 978-3-527-68799-2
ePub ISBN: 978-3-527-68798-5
Mobi ISBN: 978-3-527-68800-5
oBook ISBN: 978-3-527-68797-8
Preface
This book gives a comprehensive overview of the frontline research in pathogen detection. Infectious diseases caused by bacterial, viral, or fungal pathogens are one of the leading causes of death worldwide. In order to find the optimal treatment regime for the highly heterogeneous group of patients and to significantly reduce costs in medical care, novel tools that characterize the pathogenic microbes and the host-specific immune response are highly desired. Information about the phenotype and genotype of the germs help to accelerate quick and effective interventions, for example, the treatment of a sepsis patient with the right medication. Especially, within this context, the terms personalized medicine and pharmacogenomics, which define a stratified treatment for each individual patient, are of increasing importance. Due to a high variety in the responses of a patient panel to similar drug treatment regimes, which are caused by genetic and/or physiological variations among patients, the therapy has to be adapted to achieve highest efficiency and lowest side effects.
A plethora of analytical methods such as spanning microbiology, biochemistry, molecular biology, immunology, and biophysics are commonly applied for the detection of pathogens. Modern Techniques for Pathogen Detection informs in detail about various cutting-edge tools for pathogen identification. International scientists of the respective areas highlight recent emerging methods as well as improvements of conventional assays within individual chapters.
The management of life-threatening infections, especially sepsis, is covered, due to its importance, in a separate chapter of the book (Chapter 1). In the case of a sepsis suspicion, pathogen detection and administration of the appropriate drug combination should be performed as soon as possible. We stand at the beginning of a more personalized approach toward sepsis care. The novel developed analytical tools can facilitate an early and precise diagnosis of the pathogenic causatives of the severe infection concomitant, with profiling of their genetic status in terms of resistance to a certain antimicrobial therapy and finally also the monitoring of the treatment response.
Conventional techniques, involving microscopic or culture-based identification, enable the reliable detection of bacteria at low concentrations (Chapter 2). The morphological rating of bacteria from human patient samples combining microscopy with several classical or immunological staining techniques is an inherent part of everyday clinical practice. Beyond that, the gold standard in routine pathogen diagnostics is based on culture methods, which use selective growth media in combination with a multitude of biochemical tests. These tests are inexpensive and provide qualitative and quantitative information about the investigated pathogens. Culture-based techniques usually require an overnight incubation, thus the analysis time is extended to at least 1 day. In addition, the culture-based approach relies on the presence of culturable cells. Therefore, only the implementation of testing results from other assays provides the possibility to evaluate the pathogenic flora in case of non-culturable or slow-growing organisms.
In the last decades, molecular assays improved pathogen detection, leading to higher sensitivity, selectivity, and a significantly reduced sample-to-answer time. Nucleic acid-based techniques are discussed in detail in the relevant chapters (Chapters 3, 4, and 7). Great efforts were made to enable a simultaneous screening of several pathogens by means of multiplex nucleic acid amplification or microarray platforms. The trend to integrate automation in the molecular assay workflow has led to sample-to-answer times of several hours, depending on the employed diagnostic technique. Nevertheless, the results of PCR and microarray approaches should be critically rated in the clinical and microbiological context of the patients. An elegant assay is the direct specification of pathogens within a blood culture by means of fluorescence in situ hybridization (FISH). This approach is a follow-up staining method after the initial identification of Gram-positive or Gram-negative bacteria. A Quick-FISH testing platform can minimize the sample-to-answer time starting from Gram stain to 30 min. Of great importance is the fact that the inclusion of nucleic acid-based techniques into clinical routine depends on both the total hands-on-time and operator-friendly analysis platforms.
Furthermore, modern analytical methods, such as MALDI-TOF mass spectrometry, are discussed as a routine clinical microbiology laboratory for identification of infectious agents (Chapter 5). This fast evolving and increasingly applied technique allows the rapid and accurate identification of microorganism as well as antibiotic resistance markers based on specific biomarker signatures. Within this context, this pattern-matching process offers the balance between the time-consuming culture-based techniques and highly accurate nucleic acid-based techniques. Very promising tools for pathogen profiling are IR and Raman spectroscopic techniques, which are therefore also introduced within the book (Chapter 6). Their main advantage is given by the possibility of probing bacteria at single-cell level without any prior cultivation steps. IR and Raman spectroscopic techniques are successfully applied to identify bacteria by matching experimental molecular fingerprint information of single bacteria with reference members of the same biological species in preformed spectral databases by chemometrics. This pattern-matching approach is described for the direct classification and identification of infectious agents.
In summary, Modern Techniques for Pathogen Detection highlights state-of-the-art knowledge, emerging trends, and critical advices from experts for pathogen detection. We highly recommend the book to interdisciplinary working scientists at the nexus of fundamental research and clinical application, which plan to focus their research on further improvements that enable accurate and timely pathogen identification along with the respective antibiotic resistance information. The latter one is definitely the prerequisite to quickly adjust the right medication for a patient who suffers from severe microbial infection. A further crucial challenge for all the applied tools in terms of pathogen detection is the precise distinction of normal colonization and pathogenic invasion.
Last but not least, we would like to thank all the authors for the enjoyable cooperation that contribute to this book. The authors have a designated longtime expertise on their respective scientific area within the fast evolving field of microbial infection detection. Special thanks for their conscientious work, the abundance of patience, and the countless fruitful discussions. We would also thank the dedicated team of the publisher.
Michael BauerJürgen Popp
Jena, January 2015
List of Contributors
Till T. Bachmann
The University of Edinburgh
College of Medicine and Veterinary Medicine
Division of Infection and Pathway Medicine
Chancellor's Building
49 Little France Crescent
Edinburgh
EH16 4SB Scotland
UK
Michael Bauer
InfectoGnostics Forschungscampus Jena
Zentrum für Angewandte Forschung
Philosophenweg 7
07743 Jena
GermanyandJena University Hospital
Department of Anesthesiology and Intensive Care Medicine
Erlanger Allee 101
07747 Jena
GermanyandJena University Hospital
CSCC, Center for Sepsis Control and Care
Erlanger Allee 101
07747 Jena
Germany
Graeme N. Forrest
Portland Veterans Affairs Medical Center and Oregon Health and Science University
3710 SW US Veterans Hospital Rd
P3-ID, Portland
OR 97239
USA
Ralf Heinke
Institute of Physical Chemistry and Abbe Center of Photonics
Friedrich Schiller University Jena
Helmholtzweg 4
07743 Jena
Germany
Sandra Kloß
Institute of Physical Chemistry and Abbe Center of Photonics
Friedrich Schiller University Jena
Helmholtzweg 4
07743 Jena
Germany
Andreas Kortgen
Jena University Hospital
Friedrich-Schiller-University
Department of Anesthesiology and Intensive Care Medicine
Erlanger Allee 101
07747 Jena
GermanyandJena University Hospital
CSCC, Center for Sepsis Control and Care
Erlanger Allee 101
07747 Jena
Germany
Dragana Kusic
Institute of Physical Chemistry and Abbe Center of Photonics
Friedrich Schiller University Jena
Helmholtzweg 4
07743 Jena
Germany
Marc Lehmann
Jena University GmbH
Moldiax GmbH
Konrad-Zuse-Straße 1
07745 Jena
Germany
Bettina Löffler
University Hospital of Münster
Institute of Medical Microbiology
Domagkstr. 10
48149 Münster
Germany
Oliwia Makarewicz
Jena University Hospital
Center for Infectious Diseases and Infection Control
Erlanger Allee 101
07747 Jena
GermanyandJena University Hospital
CSCC, Center for Sepsis Control and Care
Erlanger Allee 101
07747 Jena
Germany
Claudia Stein
Jena University Hospital
Center for Infectious Diseases and Infection Control
Erlanger Allee 101
07740 Jena
Germany
Susann Meisel
Institute of Physical Chemistry and Abbe Center of Photonics
Friedrich Schiller University Jena
Helmholtzweg 4
07743 Jena
Germany
Jwan Mohammadi
Oregon Health and Science University
3181 SW Sam Jackson Park Rd, L-457
Portland
OR 97239
USA
Shahrzad Mohammadi
Portland Veterans A{f}{f}airs Medical Center and Oregon Health and Science University
3710 SW US Veterans Hospital Rd
P3-ID, Portland
OR 97239
USA
Ute Münchberg
Institute of Physical Chemistry and Abbe Center of Photonics
Friedrich Schiller University Jena
Helmholtzweg 4
07743 Jena
GermanyandJena School for Microbial
Communication
Friedrich Schiller University Jena
07743 Jena
Germany
Wolfgang Pfister
Jena University Hospital
Institute of Medical Microbiology
Erlanger Allee 101
07747 Jena
Germany
Mathias Pletz
Jena University Hospital
Center for Infectious Diseases and Infection Control
Erlanger Allee 101
07740 Jena
GermanyandJena University Hospital
CSCC, Center for Sepsis Control and Care
Erlanger Allee 101
07747 Jena
Germany
Sibyll Pollok
Abbe Center of Photonics
Friedrich-Schiller University Jena
Institute for Physical Chemistry
Helmholtzweg 4
07743 Jena
GermanyandLeibniz Institute of Photonic Technology Jena
Albert-Einstein-Straße 9
07745 Jena
GermanyandInfectoGnostics Forschungscampus Jena
Zentrum für Angewandte Forschung
Philosophenweg 7
07743 Jena
Germany
Jürgen Popp
Institute of Physical Chemistry and Abbe Center of Photonics
Friedrich Schiller University Jena
Helmholtzweg 4
07743 Jena
GermanyandLeibniz Institute of Photonic Technology Jena e. V.
Albert Einstein Straße 9
07745 Jena
GermanyandInfectoGnostics Forschungscampus Jena
Zentrum für Angewandte Forschung
Philosophenweg 7
07743 Jena
Germany
Petra Rösch
Institute of Physical Chemistry and Abbe Center of Photonics
Friedrich Schiller University Jena
Helmholtzweg 4
07743 Jena
Germany
Maya Rubtsova
M.V. Lomonosov Moscow State University
Department of Chemical Enzymology
Chemistry Faculty
Leninskie gori
119991 Moscow
Russia
Roland P.H. Schmitz
Center for Sepsis Control and Care (CSCC)
Department of Anesthesiology and Intensive Care Medicine
Jena University Hospital
Erlanger Allee 101
07747 Jena
Germany
Holger Schulze
The University of Edinburgh
College of Medicine and Veterinary Medicine
Division of Infection and Pathway Medicine
Chancellor's Building
49 Little France Crescent, Edinburgh
EH16 4SB Scotland
UK
Mervyn Singer
InfectoGnostics
Forschungscampus Jena
Zentrum für Angewandte Forschung
Philosophenweg 7
07743 Jena
GermanyandUniversity College London
Bloomsbury Institute for Intensive Care Medicine
Cruciform Building, Gower Street
WC1E 6BT, London
UK
Claudia Stein
Jena University Hospital
Center for Infectious Diseases and Infection Control
Erlanger Allee 101
07740 Jena
Germany
Stephan Stöckel
Abbe Center of Photonics
Friedrich Schiller University Jena
Institute of Physical Chemistry
Helmholtzweg 4
07743 Jena
Germany
Karina Weber
Abbe Center of Photonics
Friedrich-Schiller University Jena
Institute for Physical Chemistry
Helmholtzweg 4
07743 Jena
GermanyandLeibniz Institute of Photonic Technology Jena
Albert-Einstein-Straße 9
07745 Jena
GermanyandInfectoGnostics Forschungscampus Jena
Zentrum für Angewandte Forschung
Philosophenweg 7
07743 Jena
Germany
Stefan Zimmermann
Medical Microbiology and Hygiene
Department of Infectious Diseases
University Hospital Heidelberg
alternatively: Ruprecht Carl University Heidelberg
Im Neuenheimer Feld 324
69120 Heidelberg
Germany
1Unmet Medical Needs in Life-Threatening Infections – Caring for the Critically Ill
Michael Bauer Andreas Kortgen, and Mervyn Singer
1.1 Life Threatening Infections and Sepsis – Defining the Problem
The large number of infectious agents, complicated further by many varied pathogen- and host-specific characteristics, results in a broad spectrum of communicable diseases of which both prevention and control are challenging. While many infectious diseases are benign and are primarily treated in the community, severe infections may give rise to an urgent need to control the source of infection, to implement appropriate anti-infective therapy, and to provide supportive care to maintain homeostasis [1].
Under these conditions, the patient outcome from infection is determined not only by the invading pathogen which can be directly toxic and destructive to cells and tissues but also – or even primarily – by the host response. This host response may be inappropriately exaggerated, leading to severe tissue injury. Here, the effector molecules of immune cells, such as oxygen free-radicals and nitric oxide, cannot discriminate between microbial targets and host tissue [2]. Indeed, a novel concept has been proposed to describe the development of organ failure, that is, severe sepsis, as a disturbed “disease tolerance” where the eventual development of organ dysfunction is considered an inability to establish an appropriate equilibrium between direct pathogen damage and the ensuing host response (Figure 1.1) [3]. Patients with an uncontrolled focus of infection or an exuberant host response are particularly prone to develop organ dysfunction requiring care in a specialized “intensive care unit (ICU).” Such patients are referred to as septic (Figure 1.2).
Figure 1.1 Evolving concepts of sepsis as a “host defense failure disease.” The host response to invading pathogens requires a cytotoxic response that can result in a trade-off where tolerance of a pathogen may be associated with less organ injury.
Figure 1.2 Activation of the innate immune system as a “double-edged sword.” Activation of innate immunity reflects a prerequisite for defense and repair of a septic focus, such as a perforated viscus. However, this may lead to collateral damage if spillover of inflammatory mediators or release of activated cells into the systemic circulation occurs.
Lesen Sie weiter in der vollständigen Ausgabe!
Lesen Sie weiter in der vollständigen Ausgabe!
Lesen Sie weiter in der vollständigen Ausgabe!
Lesen Sie weiter in der vollständigen Ausgabe!
Lesen Sie weiter in der vollständigen Ausgabe!
Lesen Sie weiter in der vollständigen Ausgabe!
Lesen Sie weiter in der vollständigen Ausgabe!
Lesen Sie weiter in der vollständigen Ausgabe!
Lesen Sie weiter in der vollständigen Ausgabe!
Lesen Sie weiter in der vollständigen Ausgabe!





























